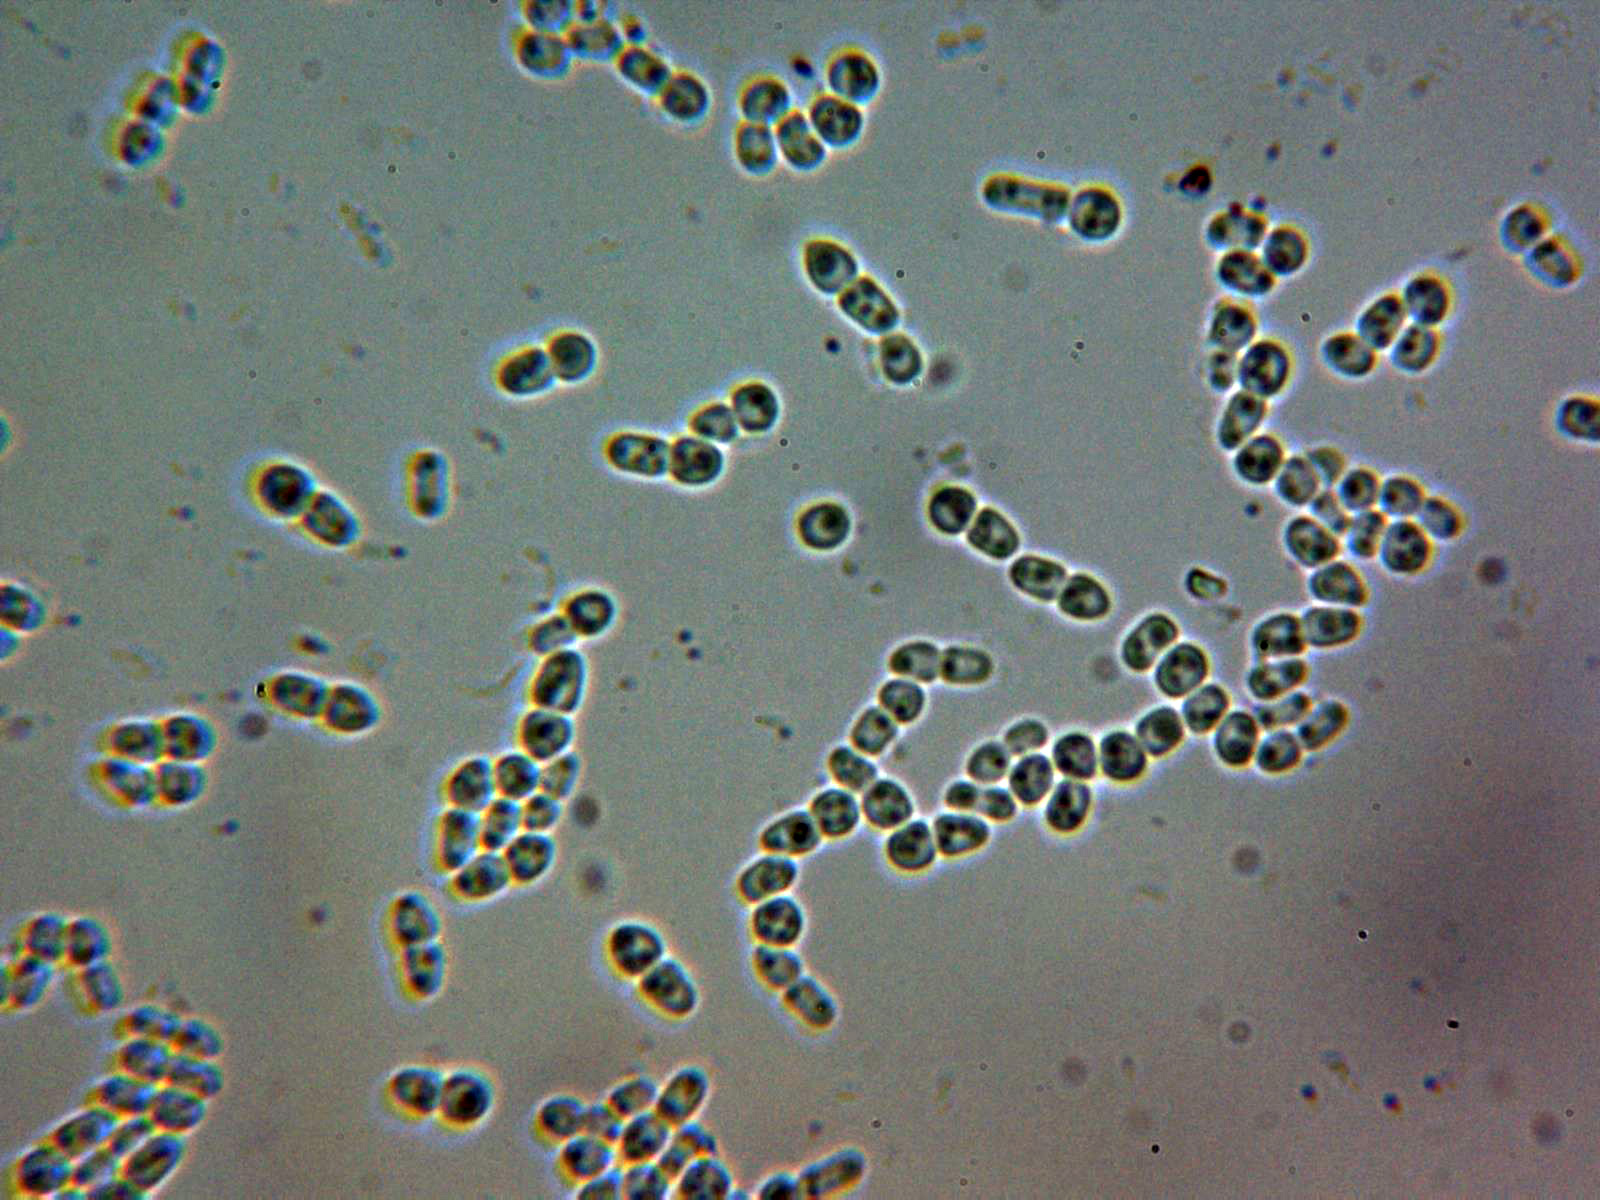

Hypocrea atlantica.......probablemente
Hypocrea atlantica.......probablemente
- Josep Torres
-
 Autor del tema
Autor del tema
- Fuera de línea
- Moderador
-

Menos
Más
- Mensajes: 8746
- Gracias recibidas: 8379
4 años 7 meses antes #106022
por Josep Torres
Hypocrea atlantica.......probablemente Publicado por Josep Torres
Hola a tod@s.
Unos pequeños apotecios fotografiados el pasado 8 de Agosto sobre la superficie de un tronco de Fagus sylvatica.
Hypocrea atlantica Jaklitsch (2011)
Anamorfo: Trichoderma atlanticum.
Apotecios en forma de disco de tan solo entre 1,1 a 3,8 mm. de diámetro (aunque según bibliografía pueden llegar a los 5 mm., de poco grosor (poco más de 1 mm.) de color blanco en una primera fase para ir adquiriendo tonos rosados con el desarrollo.
Un par de ampliaciones a 20 aumentos:
En el momento de la recogida los ejemplares se hallaban inmaduros y no eran aún visibles los puntos ostiolares.
Estos puntos ostiolares si que eran visibles a tan solo 100 aumentos, una imágen de estos en Rojo Congo diluido:
Y otra imágen de los puntos ostiolares en agua:
Una imágen de las hifas del himenio de un ejemplar inmaduro en Rojo Congo diluido, antes de la formación de los ascos:
Y otra imágen de lo mismo en esta ocasión en agua:
A los pocos días de incubar la muestra los ejemplares ya habían cambiado de aspecto pasando a un color marrón claro:
Un ampliación a 20 aumentos donde ya se observan los ostiolos, y en el círculo de la parte baja el anamorfo con un color verdoso debido a la acumulación de conidios:
Un par de imágenes ya secos y a 40 aumentos, de color marrón rojizo oscuro:
Tejido subperitecial epidermoideo en agua con hifas de pared gruesa:
Tejido subperitecial en Reactivo de Melzer:
Himenio de un ejemplar ya desarrollado a 400 aumentos:
Ascos en Rojo Congo diluido, en su interior se pueden observar sus esporas dimórficas:
Ascos en agua destilada:
Detalle de la base de los ascos con uncínulos (Croziers)
Esporada en masa de color blanco a muy ligeramente ocrácea.
Ascosporas de dos formas, algo verrucosas y de pequeño tamaño, con unas medidas en agua de:
(3.1) 3.3 - 4 (4.1) × (1.9) 2.4 - 3.1 (3.4) µm
Q = (1) 1.1 - 1.6 (1.9) ; N = 50
Me = 3.6 × 2.7 µm ; Qe = 1.3
Estas medidas parecen encajar con las que se citan para la especie de (3,0–) 3,3–4,0 (–5,3) × (2,5–) 3,0–3,5 (–4,0) μm.
Especie propia de la madera de Fagus sylvatica y en muchos casos asociada a hongos que aparecen sobre la misma. Muy parecida tanto en el aspecto microscópico como en el molecular a la Hypocrea minutispora con la que comparte hábitat, esta última con un grosor de los apotecios de hasta 2,5 mm. y ascosporas de mayor tamaño (3,7–) 4,0–4,8 (–6,0) × (3,2–) 3,5–4,0 (–5,0) μm.
Estudio contrastado con el documento de Marzo 2011 "European species of Hypocrea part II: species with hyaline ascospores"
Saludos a tod@s.
Unos pequeños apotecios fotografiados el pasado 8 de Agosto sobre la superficie de un tronco de Fagus sylvatica.
Hypocrea atlantica Jaklitsch (2011)
Anamorfo: Trichoderma atlanticum.
Apotecios en forma de disco de tan solo entre 1,1 a 3,8 mm. de diámetro (aunque según bibliografía pueden llegar a los 5 mm., de poco grosor (poco más de 1 mm.) de color blanco en una primera fase para ir adquiriendo tonos rosados con el desarrollo.
Un par de ampliaciones a 20 aumentos:
En el momento de la recogida los ejemplares se hallaban inmaduros y no eran aún visibles los puntos ostiolares.
Estos puntos ostiolares si que eran visibles a tan solo 100 aumentos, una imágen de estos en Rojo Congo diluido:
Y otra imágen de los puntos ostiolares en agua:
Una imágen de las hifas del himenio de un ejemplar inmaduro en Rojo Congo diluido, antes de la formación de los ascos:
Y otra imágen de lo mismo en esta ocasión en agua:
A los pocos días de incubar la muestra los ejemplares ya habían cambiado de aspecto pasando a un color marrón claro:
Un ampliación a 20 aumentos donde ya se observan los ostiolos, y en el círculo de la parte baja el anamorfo con un color verdoso debido a la acumulación de conidios:
Un par de imágenes ya secos y a 40 aumentos, de color marrón rojizo oscuro:
Tejido subperitecial epidermoideo en agua con hifas de pared gruesa:
Tejido subperitecial en Reactivo de Melzer:
Himenio de un ejemplar ya desarrollado a 400 aumentos:
Ascos en Rojo Congo diluido, en su interior se pueden observar sus esporas dimórficas:
Ascos en agua destilada:
Detalle de la base de los ascos con uncínulos (Croziers)
Esporada en masa de color blanco a muy ligeramente ocrácea.
Ascosporas de dos formas, algo verrucosas y de pequeño tamaño, con unas medidas en agua de:
(3.1) 3.3 - 4 (4.1) × (1.9) 2.4 - 3.1 (3.4) µm
Q = (1) 1.1 - 1.6 (1.9) ; N = 50
Me = 3.6 × 2.7 µm ; Qe = 1.3
Estas medidas parecen encajar con las que se citan para la especie de (3,0–) 3,3–4,0 (–5,3) × (2,5–) 3,0–3,5 (–4,0) μm.
Especie propia de la madera de Fagus sylvatica y en muchos casos asociada a hongos que aparecen sobre la misma. Muy parecida tanto en el aspecto microscópico como en el molecular a la Hypocrea minutispora con la que comparte hábitat, esta última con un grosor de los apotecios de hasta 2,5 mm. y ascosporas de mayor tamaño (3,7–) 4,0–4,8 (–6,0) × (3,2–) 3,5–4,0 (–5,0) μm.
Estudio contrastado con el documento de Marzo 2011 "European species of Hypocrea part II: species with hyaline ascospores"
Saludos a tod@s.
Adjuntos:
El siguiente usuario dijo gracias: Juan Andrés Román
Por favor, Identificarse para unirse a la conversación.
- Juan Andrés Román
-

- Fuera de línea
- Spammer
-

Menos
Más
- Mensajes: 2558
- Gracias recibidas: 2756
4 años 7 meses antes #106063
por Juan Andrés Román
Respuesta de Juan Andrés Román sobre el tema Hypocrea atlantica.......probablemente
Pues probablemente lo será..................
Saludos.
Saludos.
El siguiente usuario dijo gracias: Josep Torres
Por favor, Identificarse para unirse a la conversación.
Tiempo de carga de la página: 0.366 segundos

Foro de micología